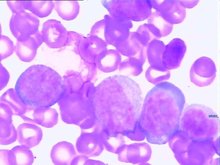
原发性中枢神经系统血管炎

陈水扁保外就医赴医检查 呛咳严重眼神显呆滞
462x550 - 99KB - JPEG
收治2例 不能硬拔-筷子 宝宝吃 中枢神经系统感
530x396 - 40KB - JPEG
收治2例 不能硬拔-筷子 宝宝吃 中枢神经系统感
530x665 - 53KB - JPEG
收治2例 不能硬拔-筷子 宝宝吃 中枢神经系统感
530x708 - 96KB - JPEG
收治2例 不能硬拔-筷子 宝宝吃 中枢神经系统感
530x397 - 30KB - JPEG

原发性中枢神经系统血管炎
220x237 - 11KB - JPEG

DeJong神经系统检查
268x378 - 20KB - JPEG

上海蓝十字脑科医院神经外科病例讨论会记录
500x333 - 651KB - PNG

舌咽神经痛_360百科
500x282 - 28KB - JPEG

女性七种情况一定要检查内分泌
400x294 - 12KB - JPEG
原发性中枢神经系统血管炎
220x165 - 10KB - JPEG

DeMyer神经系统检查
268x378 - 27KB - JPEG

神经系统细胞学检查
220x207 - 88KB - PNG

浙江永康神经系统疾病专病队列研究调查工作
500x375 - 37KB - JPEG

前庭功能检查法
270x260 - 12KB - JPEG
腾讯视频 电视剧 综艺 电影 VIP影院 动漫 新闻 知否知否应是绿肥红瘦 体格检查-08 神经系统检查(39分钟)
腾讯视频 电视剧 综艺 电影 VIP影院 动漫 教育 知否知否应是绿肥红瘦 大江大河 喜欢你时风好神经系统检查
全身查体(神经系统检查) 火石408 相关推荐 推荐出品人 全部出品人 美女直播 共 0 条评论搜狐视频TV版
神经系统检查 神经系统检查 4:47 广告 广告 广告 了解详情> 35 去广告 0 秒后抱歉,您观看的视频加载失败
神经系统检查—在线播放—《神经系统检查》—教育—优酷网,视频高清在线观看 相关精彩视频 42:54
上传视频 视频管理 我的自频道 数据分析 立即下载 下载PC客户端,上传视频更轻松!客户端 神经系统检查
神经系统检查治疗诊断方法,精神病学课件下载,精品课程,神经系统检查(examination of the nervous system)
2014贺银成通关大讲堂视频实践技能06神经系统检查 本视频由 艾札力28643 声明原创。艾札力28643 170
按住视频可进行拖动 电影 电视剧 综艺 VIP 导航 娱乐 资讯 电影 网络体格检查:神经系统检查